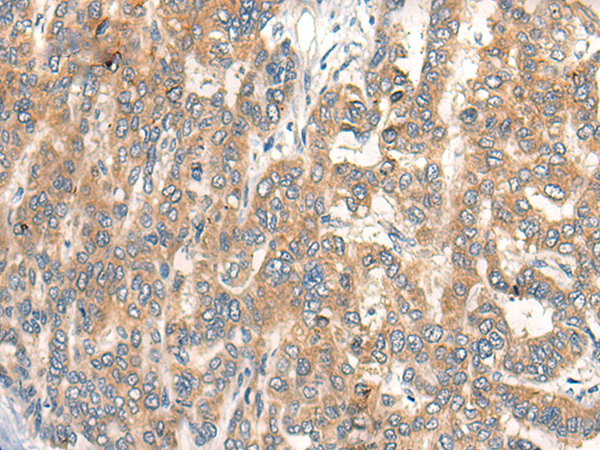

中文名稱:兔抗CP多克隆抗體
|
Background: |
The protein encoded by this gene is a metalloprotein that binds most of the copper in plasma and is involved in the peroxidation of Fe(II)transferrin to Fe(III) transferrin. Mutations in this gene cause aceruloplasminemia, which results in iron accumulation and tissue damage, and is associated with diabetes and neurologic abnormalities. Two transcript variants, one protein-coding and the other not protein-coding, have been found for this gene. |
|
Applications: |
ELISA, IHC |
|
Name of antibody: |
CP |
|
Immunogen: |
Synthetic peptide of human CP |
|
Full name: |
ceruloplasmin |
|
Synonyms: |
CP-2 |
|
SwissProt: |
P00450 |
|
ELISA Recommended dilution: |
5000-10000 |
|
IHC positive control: |
Human liver cancer |
|
IHC Recommend dilution: |
25-100 |
購(gòu)物車
購(gòu)物車 幫助
幫助
 021-54845833/15800441009
021-54845833/15800441009
